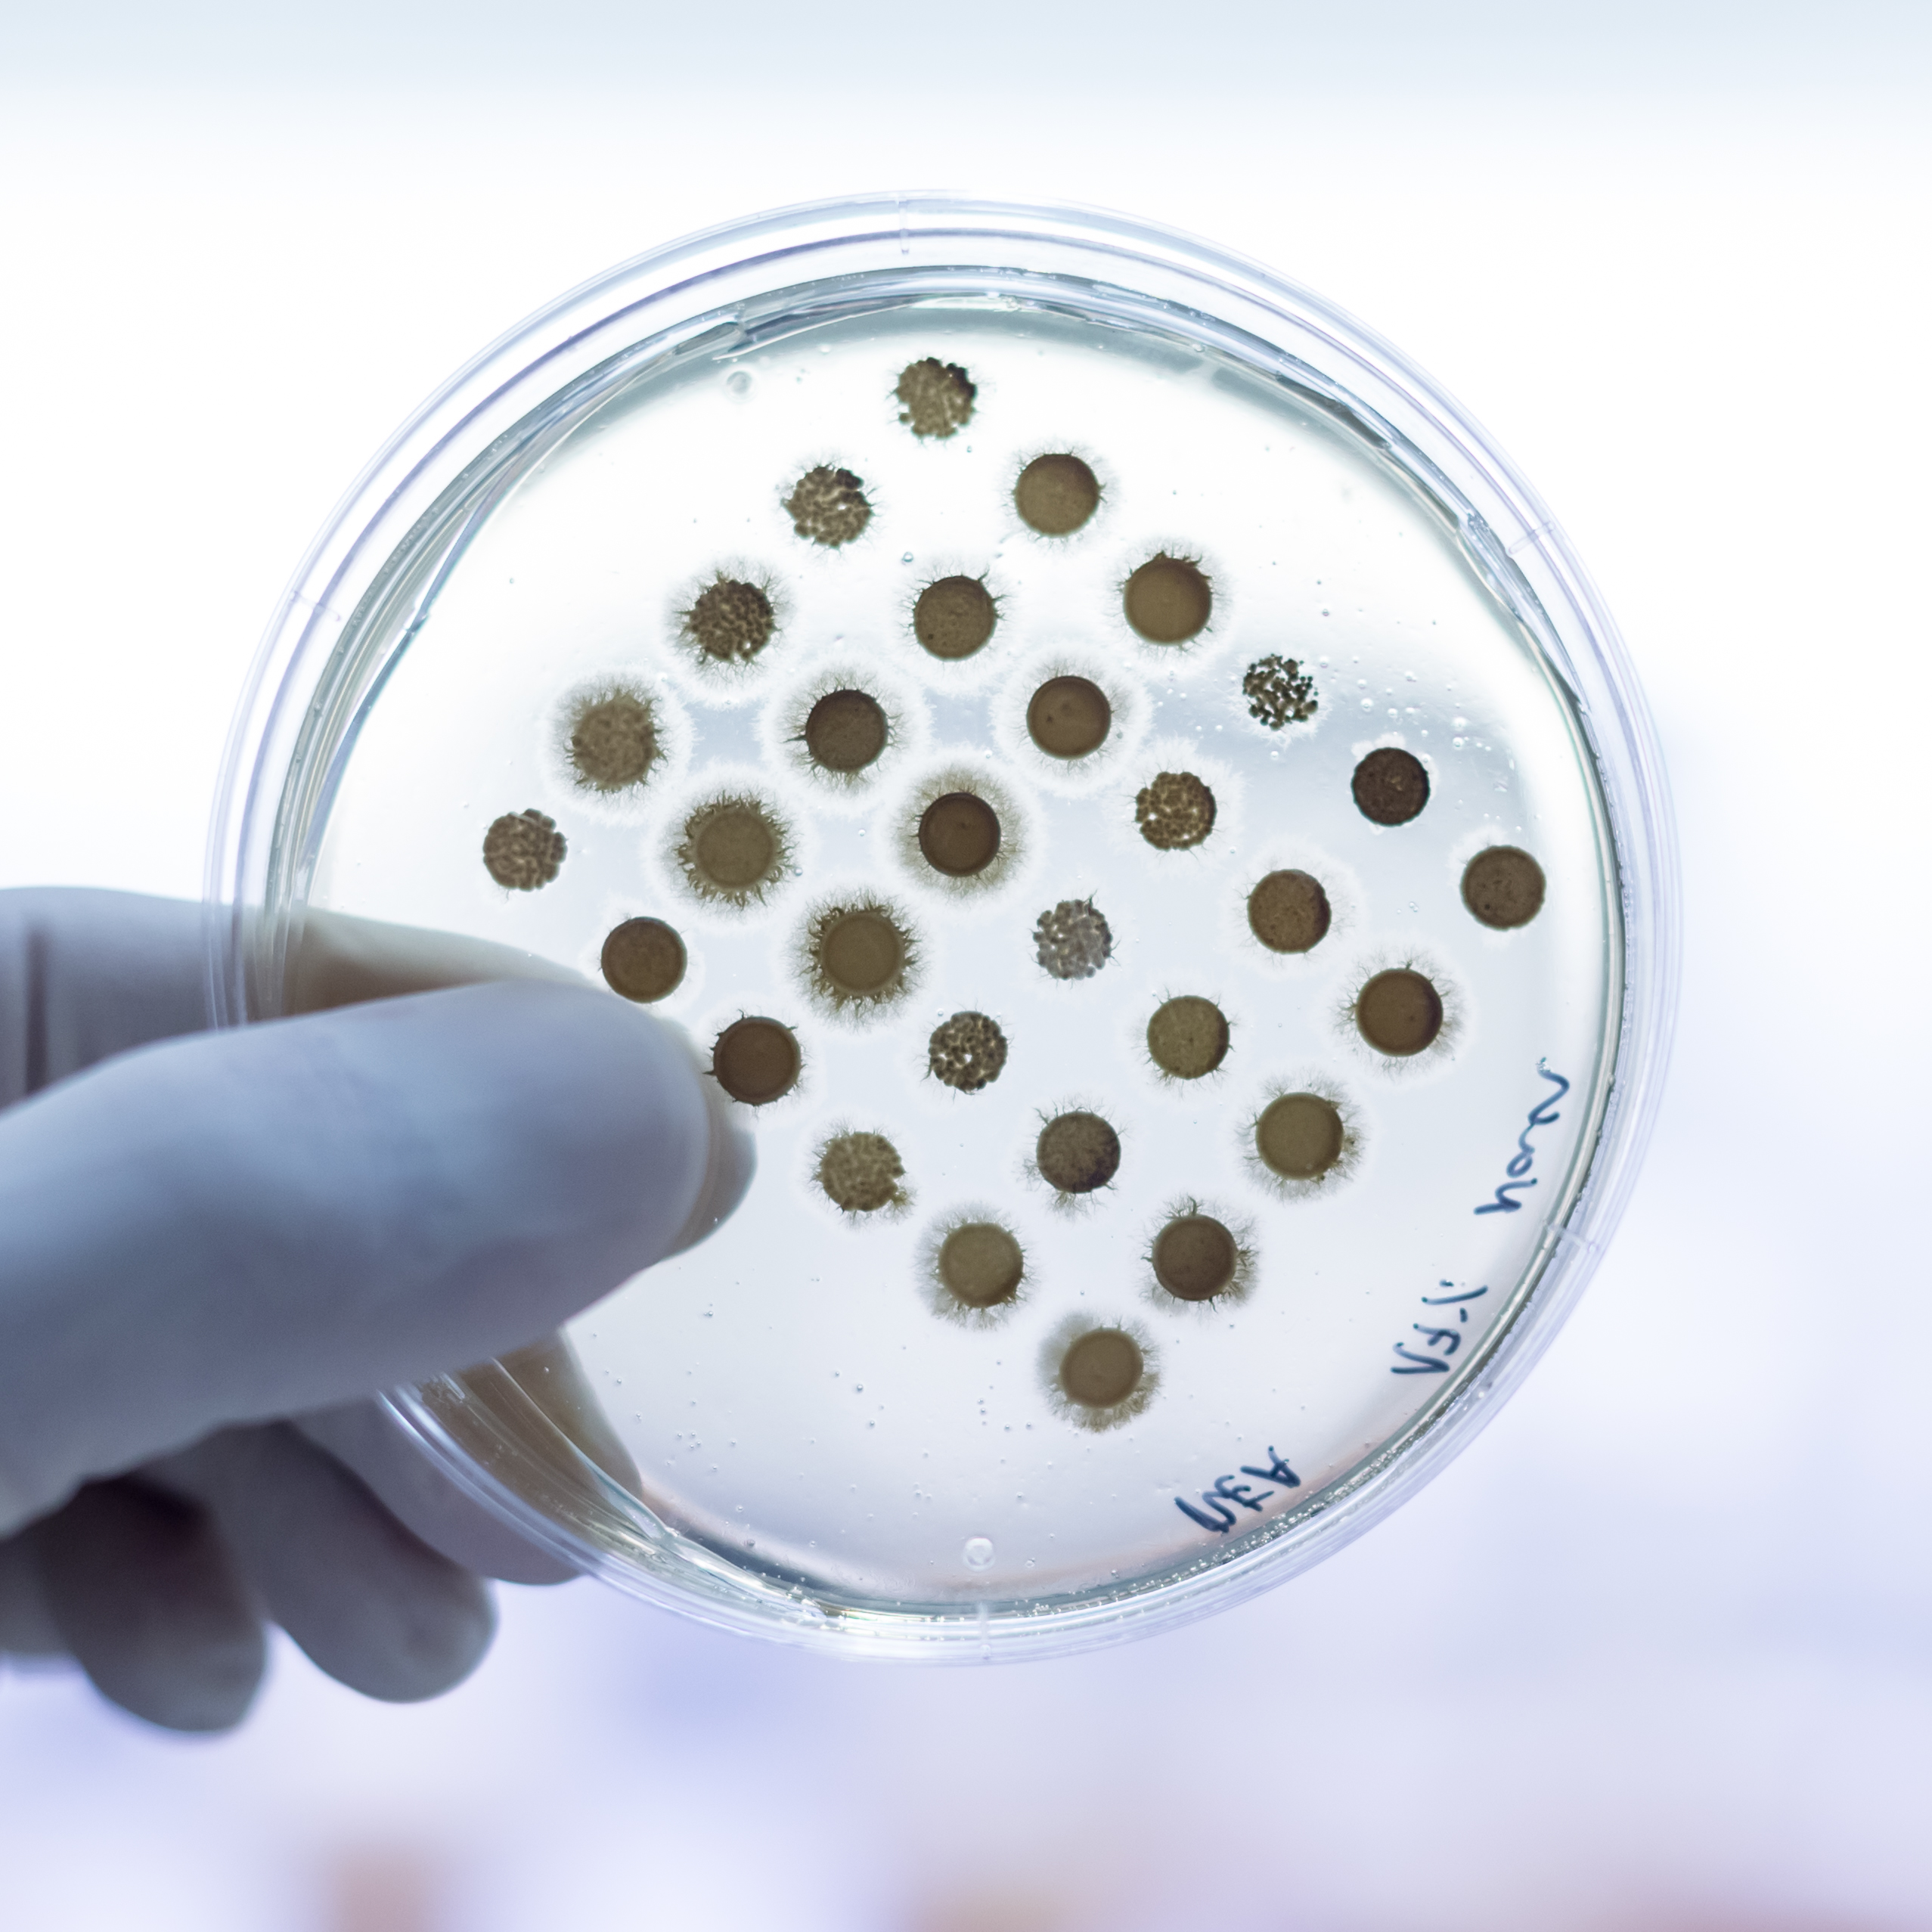
„Lücke in der Entwicklung neuer antimikrobieller Wirkstoffe wird größer“

Kategorie: Allgemein
- Mein liebes Tagebuch
Wie die Abda mit einem Brief zwar nicht ans Christkind, aber an Nina Warken versucht, das Ministerium für eine Fixumserhöhung und eine Abkehr von der PTA-Vertretungsbefugnis zu bewegen. Währenddessen sieht die Apothekerkammer Westfalen-Lippe ein, dass die Abda mehr Professionalisierung braucht und gründet eine Arbeitsgruppe zur Veränderung der Abda-Struktur. Und es gibt noch ein No Go… Mein liebes Tagebuch weiterlesen - Apfel gegen Apfel
Willkommen zum DAZ-Adventsrätsel am zweiten Adventssonntag! Heute geht es nicht um Arzneimittel, sondern um das typische Randsortiment der Apotheke. Genauer: um Zahnpasta. Und um Obst. - Dr. Morton Douglas über einen Yeti
Nicht nur Alpinisten berichten von Yetis – es gibt sie auch in der Juristerei. Dies sind Vorschriften, von denen viele gehört haben, doch niemand sie eigentlich anwendet. Eine solche dürfte auch § 73 Abs. 1 Satz 3 AMG sein, in dem die Existenz der sogenannten Länderliste normiert wird. Da in der jüngeren Vergangenheit vermehrt über… Dr. Morton Douglas über einen Yeti weiterlesen - Wer bin ich?
Im heutigen DAZ-Adventsrätsel geht es um einen Markenbotschafter, der sich wahrscheinlich als Stofftier in den meisten Apotheken findet. Doch welche Figur suchen wir? - Borkenflechte: Hochansteckend und honigfarben
„Wir haben Borkenflechte in der Kita”. Wenn Eltern diese Info erhalten, sind sie oft ratlos. Was hinter der Borkenflechte steckt, wie man sie vorbeugen und behandeln kann, haben wir für Sie zusammengefasst.